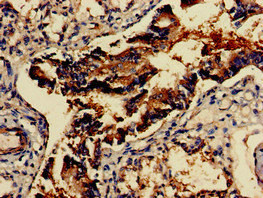

GAD2 Antibody
-
中文名稱:GAD2兔多克隆抗體
-
貨號:CSB-PA11159A0Rb
-
規(guī)格:¥440
-
圖片:
-
Western Blot
Positive WB detected in: Mouse lung tissue, Mouse stomach tissue
All lanes: GAD2 antibody at 2.7μg/ml
Secondary
Goat polyclonal to rabbit IgG at 1/50000 dilution
Predicted band size: 66 kDa
Observed band size: 66 kDa -
Immunohistochemistry of paraffin-embedded human brain tissue using CSB-PA11159A0Rb at dilution of 1:100
-
Immunohistochemistry of paraffin-embedded human lung tissue using CSB-PA11159A0Rb at dilution of 1:100
-
-
其他:
產(chǎn)品詳情
-
產(chǎn)品名稱:Rabbit anti-Homo sapiens (Human) GAD2 Polyclonal antibody
-
Uniprot No.:
-
基因名:
-
別名:65 kDa glutamic acid decarboxylase antibody; DCE 2 antibody; DCE2 antibody; DCE2_HUMAN antibody; GAD 2 antibody; GAD 65 antibody; GAD-2 antibody; GAD-65 antibody; Gad2 antibody; Glutamate decarboxylase 2 (pancreas) antibody; Glutamate Decarboxylase 2 (pancreatic islets and brain 65kDa) antibody; Glutamate decarboxylase 2 antibody; Glutamate Decarboxylase 65 antibody; Glutamate decarboxylase 65 kDa isoform antibody; Glutamic Acid Decarboxylase 2 antibody; Glutamic Acid Decarboxylase 65 antibody; MGC161605 antibody; MGC161607 antibody
-
宿主:Rabbit
-
反應種屬:Human, Mouse
-
免疫原:Recombinant Human Glutamate decarboxylase 2 protein (1-82AA)
-
免疫原種屬:Homo sapiens (Human)
-
標記方式:Non-conjugated
本頁面中的產(chǎn)品,GAD2 Antibody (CSB-PA11159A0Rb),的標記方式是Non-conjugated。對于GAD2 Antibody,我們還提供其他標記。見下表:
-
克隆類型:Polyclonal
-
抗體亞型:IgG
-
純化方式:>95%, Protein G purified
-
濃度:It differs from different batches. Please contact us to confirm it.
-
保存緩沖液:Preservative: 0.03% Proclin 300
Constituents: 50% Glycerol, 0.01M PBS, pH 7.4 -
產(chǎn)品提供形式:Liquid
-
應用范圍:ELISA, WB, IHC
-
推薦稀釋比:
Application Recommended Dilution WB 1:500-1:5000 IHC 1:20-1:200 -
Protocols:
-
儲存條件:Upon receipt, store at -20°C or -80°C. Avoid repeated freeze.
-
貨期:Basically, we can dispatch the products out in 1-3 working days after receiving your orders. Delivery time maybe differs from different purchasing way or location, please kindly consult your local distributors for specific delivery time.
-
用途:For Research Use Only. Not for use in diagnostic or therapeutic procedures.
相關產(chǎn)品
靶點詳情
-
功能:Catalyzes the production of GABA.
-
基因功能參考文獻:
- In individuals with adult-onset diabetes, presence of N-terminally truncated GAD65 autoantibodies is associated with the clinical phenotype of autoimmune type 1 diabetes and predicts insulin therapy. PMID: 29619531
- This study showed a significant 58% increase of SCN GAD65/67-ir and a significant 169% increase of SCN GAD67-mRNA in the depression group. PMID: 28608287
- healthy donor NK cells showed similar degranulation against both GAD65 AA 114-122 pulsed and unpulsed APCs. The pathogenetic significance of the CD3-CD8dullCD56+ 'memory-like NK cell subset' with increased response upon secondary challenge in diabetics remains to be elucidated PMID: 29236750
- Genetic variability in GAD2 and GAD1 contributes to risk of methamphetamine dependence in the Thai population. PMID: 27967329
- Study propose that aberrant accumulation of immunogenic GAD65 in Golgi membranes facilitates inappropriate presentation to the immune system after release from stressed and/or damaged beta-cells, triggering autoimmunity. PMID: 27284108
- UV exposed hydrogen peroxide produces hydroxyl radical that may cause protein damage (GAD-65) to the extent of generating neo-epitopes on the molecule, making it immunogenic. PMID: 26362234
- we investigated the relationship between serum glutamic acid decarboxylase (GAD) autoantibody (Ab) levels and single nucleotide polymorphisms (SNPs) of the glutamic acid de-carboxylase 2 (GAD2) 5'-untranslated region PMID: 25966064
- Kaplan-Meier survival curves estimated a worst pancreas graft survival for patients with positive IA-2 antibodies versus those patients with negative auto-antibodies and GAD65+ auto-antibodies after simultaneous pancreas kidney transplantation. PMID: 25645784
- Plasma GAD65 qualifies as a marker for early beta-cell loss after intraportal transplantation. PMID: 25816051
- Cohort study shows that mean GAD65 mRNA levels in the prefrontal cortex area 9 are not altered in subjects with schizophrenia but are lower in subjects with schizoaffective disorder PMID: 24993056
- Data suggest that women with gestational diabetes who develop autoantibodies against GAD2 (glutamate decarboxylase 2) exhibit higher blood glucose levels, insulin resistance, and impaired insulin secretion from beta cells in the postpartum period. PMID: 25345799
- GAD2 SNPs significantly associate with early-onset obsessive compulsive disorder. PMID: 24571444
- There is a marked gender dimorphism in GAD65 positivity, higher in obstructive sleep apnoea syndrome females vs. males. PMID: 24661757
- GAD65 expression in 313 gastric cancer tissues was significantly higher than in 60 adjacent non-tumour tissues. Moreover, the expression level of GAD65 significantly correlated with the depth of tumour invasion and TNM stage. PMID: 23822856
- GAD65 is severely reduced in Alzheimer's disease middle temporal gyrus, hippocampus and putamen neuropil granules. PMID: 23114513
- The study demonstrated a statistically significant difference in the frequency of the GAD2 (+83987 T/A) genes between obese patients and controls in Taiwanese subjects. PMID: 22366823
- Decreased expression of GAD65 protein within inhibitory boutons could contribute to auditory impairments in schizophrenia. PMID: 22624794
- In latent autoimmune diabetic subjects, high GAD antibody titer was associated with a profile of more severe autoimmunity and, in male gender, specifically predisposed to thyroid autoimmunity. PMID: 22865904
- The presence of GADA post partum was positively associated with diabetes post partum (p=0.0009), but not with impaired glucose tolerance PMID: 22104260
- GAD65 palmitoylation is important for the delivery of GAD65 to inhibitory synapses and suggest that impairment of GAD65 palmitoylation by mhtt may lead to altered inhibitory neurotransmission in Huntington's disease. PMID: 22103299
- ZnT8A, GADA and IA-2A are autoantibodies that may have a role in successful pancreas graft survival PMID: 21792090
- Results describe the gross distribution patterns of GAD65 in human and rhesus monkey thalami and show that they are nearly identical. PMID: 21491431
- From midgestation to infancy, the pattern of GABAA receptor binding changed from uniformly low across all cortical layers to high levels concentrated in the middle laminae;GAD65 levels differentially increased. PMID: 21937910
- the IgG subclass profile of anti-GAD65 Ab in healthy individuals differs from that in Type 1 Diabetes Patients. PMID: 21517929
- Studies indicate that T1DM can be detected by determining four autoantibodies, namely those antibodies against insulin, glutamic acid decarboxylase 65, insulinoma antigen (IA)-2 (ICA512) and the zinc transporter ZnT8. PMID: 21073664
- Data suggest that regulation of ROS-GADAbs could offer novel tools for analysing and possibly treating T1D complications. PMID: 21385406
- The GAD 65 antigen could be identified in 8 patient sera: 4 children with diabetes mellitus type 1 and 4 adults initially taken as controls but who retrospectively showed signs of autoimmunity. PMID: 20016201
- Peptides in rotavirus VP7, similar to T cell epitopes in IA2 and GAD65, bind strongly to HLA-DRB1*04 molecules that confer susceptibility to type 1 diabetes and are also T cell epitopes in humans at risk for type 1 diabetes. PMID: 20083660
- The number of human pancreatic islet cells expressing CGRP, GABA and GAD decreased significantly after the onset of Type 2 diabetes PMID: 20010500
- behavioral inhibition-associated SNPs appear to be associated with differences in MYO3A- but not GAD2 lymphoblastoid-mRNA expression levels PMID: 19229853
- Molecular mimicry in type 1 diabetes: immune cross-reactivity between islet autoantigen and human cytomegalovirus but not Coxsackie virus. PMID: 12021098
- The PEVKEK region of the pyridoxal phosphate binding domain of GAD65 expresses a dominant B cell epitope for type 1 diabetes sera PMID: 12021103
- GAD65-specific B cells and the antibodies they secrete appear to modulate the autoimmune T cell repertoire by down-regulating T cell epitopes in an immunodominant area while boosting epitopes in distant or cryptic regions. PMID: 12097368
- GAD2 in type 1 diabetes. GAD2 does not play a major role in type 1 diabetes in these two European populations. PMID: 12196483
- The effect of GAD65 on T-cell activation in stiff-man syndrome and cerebellar ataxia associated with polyendocrine autoimmunity was evaluated. PMID: 12197888
- The alpha-helical secondary structure of the GAD65 C-terminus must be denatured to generate linear epitopes. The N-terminus is both surface-exposed and linear in the native structure. Masking membrane interactions must be broken for B-cell recognition. PMID: 12296864
- dinucleotide repeat polymorphism in GAD65 PMID: 12503190
- results support the hypothesis that presentation of GAD autoantigen by islet endothelium in vivo could promote transmigration of circulating islet autoantigen-specific T-cells primed in regional lymph nodes against islet autoantigens PMID: 12606513
- GAD antibodies in type I diabetes mellitus has unique N-terminal linear epitopes that are located on the anchoring domain of GAD65 molecules. PMID: 14557453
- Data suggest that the conversion of full-length glutamate decarboxylase (GAD) to truncated GAD65 mediated by endogenous protease may represent an important mechanism in the regulation of GABA biosynthesis in the brain. PMID: 14576464
- GAD2 is mapped to chromosome 10p12 and is a candidate gene for human obesity PMID: 14691540
- The StyI polymorphism in intron 11 of GAD2 did not associate with schizophrenia or suicidal ideation/behavior. PMID: 15091314
- highly heterogeneous recognition of a multitude of INS and GAD65 peptide determinants occurred in the absence of protein recognition, and low functional avidity of the memory T cells PMID: 15163889
- Among the type 1 diabetes children, increasing neutralising titres was associated positively with increasing antibody levels against GAD65. All siblings with antibodies against GAD 65 had significant titre increase against any of the CBV strains. PMID: 15170642
- specificity and avidity of GAD65 reactive T-cell clones isolated from patients with type 1 diabetes PMID: 15277377
- Conformation-dependent autoantibodies directed against GAD65 are markers of Type 1 diabetes. PMID: 15365614
- GAD65 autoantibody response in the preclinical stage of type 1 diabetes is dynamic and related to the HLA genotypes that confer risk of diabetes. PMID: 15834701
- Site-directed mutagenesis study validates that cysteine-446 (present in GAD65 as a free sulfhydryl group) plays an important role in GAD65 activity. PMID: 15836621
- Out of 14 GAD2 markers screened in stage 1, only one met the threshold criteria for follow-up in a range of anxiety disorders and major depression PMID: 16718280
- marginally significant (0.01 < P < 0.05) associations between four common variants of GAD2 and BMI were observed PMID: 16731858
顯示更多
收起更多
-
亞細胞定位:Cytoplasm, cytosol. Cytoplasmic vesicle. Cell junction, synapse, presynaptic cell membrane; Lipid-anchor. Golgi apparatus membrane; Peripheral membrane protein; Cytoplasmic side. Note=Associated to cytoplasmic vesicles. In neurons, cytosolic leaflet of Golgi membranes and presynaptic clusters.
-
蛋白家族:Group II decarboxylase family
-
數(shù)據(jù)庫鏈接:
Most popular with customers
-
-
YWHAB Recombinant Monoclonal Antibody
Applications: ELISA, WB, IHC, IF, FC
Species Reactivity: Human, Mouse, Rat
-
Phospho-YAP1 (S127) Recombinant Monoclonal Antibody
Applications: ELISA, WB, IHC
Species Reactivity: Human
-
-
-
-
-